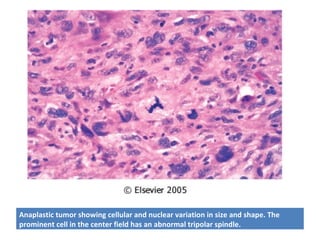
Anaplastic tumor showing cellular and nuclear variation in size and shape. The
prominent cell in the center field has an abnormal tripolar spindle.

El documento define varios términos relacionados con las neoplasias y los tumores. Explica que una neoplasia es una masa anormal de tejido con crecimiento excesivo. Define tumores como crecimientos histológicos caracterizados por proliferación celular descontrolada. Distingue entre tumores benignos y malignos, y explica que los malignos tienden a invadir tejidos circundantes y metastatizarse. También define conceptos como anaplasia, metaplasia y metástasis.